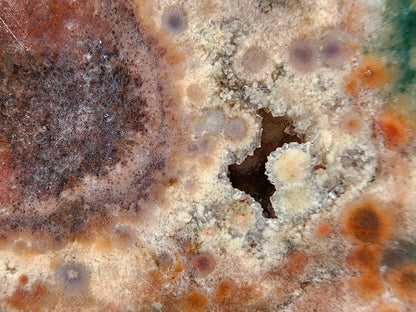
Poppy Agate
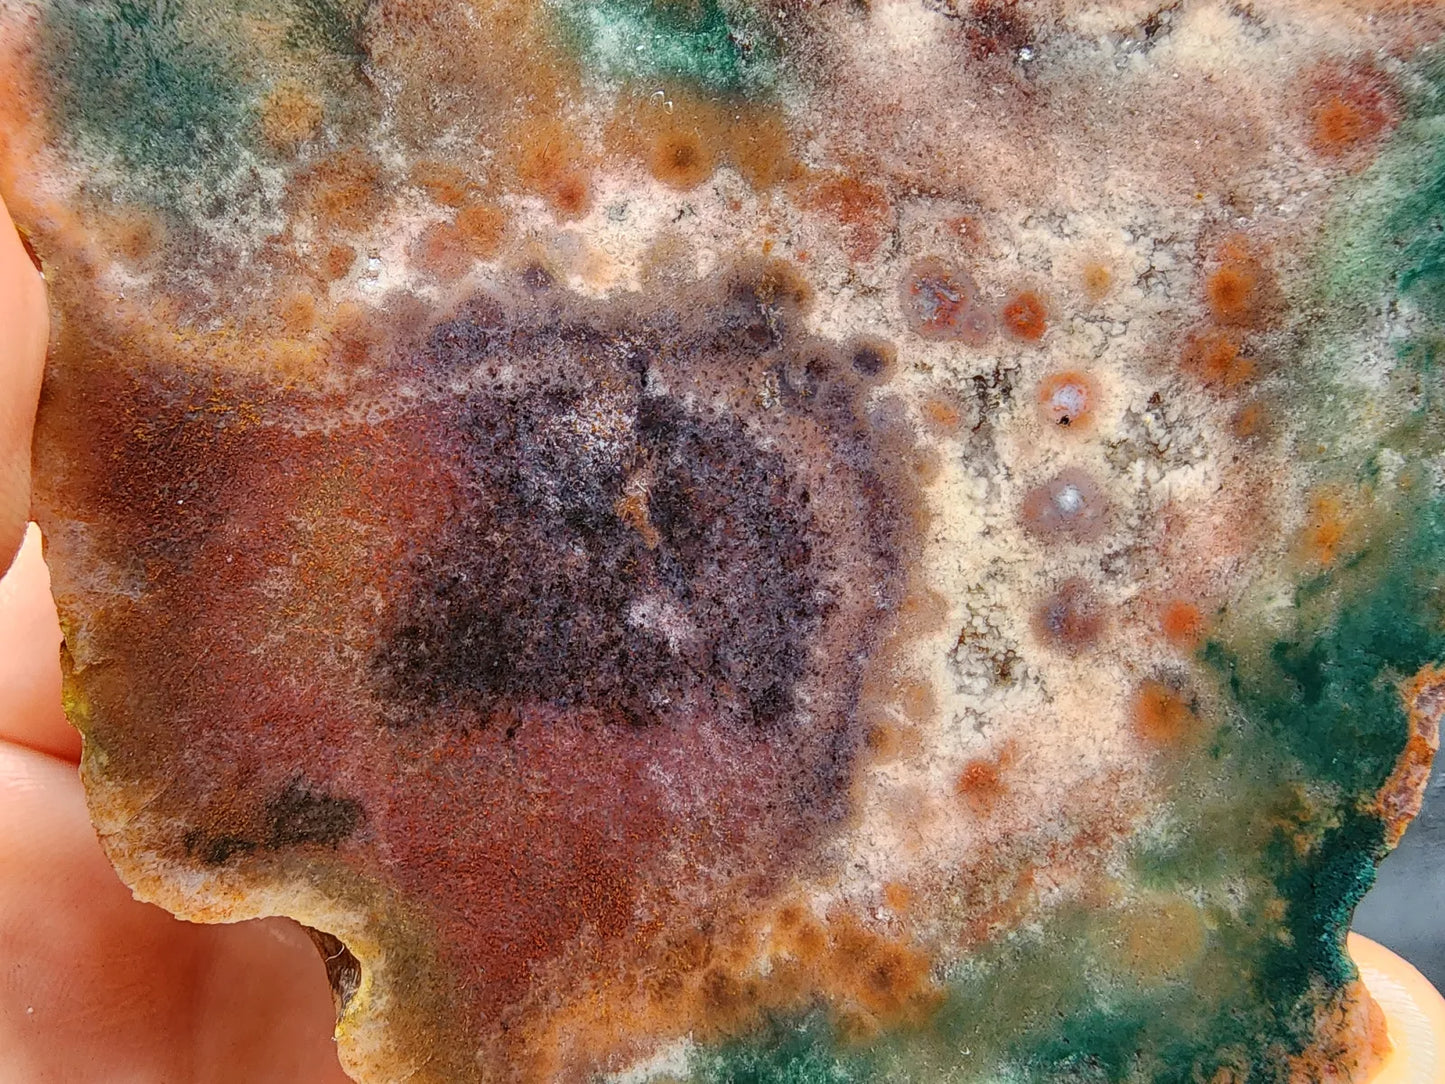
Poppy Agate

This listing is for an unpolished, undyed, 100% natural spotted agate / poppy agate pair weighing a total of 15.27 oz (433 oz). The first nine pictures and video were taken outdoors with the collectable agate wet (not under direct sunlight); the rest, indoors and dry. We did not apply any filters to the photos or video, before or after taking them.
IMPORTANT 👉 When you receive this oddball agate pair, the colors will look like they do in the weight and dimension photos. You can polish them yourself, or have them polished. Or, as some prefer, not polish them at all -- completely up to you.
This spotted agate pair is also a healing stone -- it's perfect for chakra alignment, manifestation, and divination if you are spiritually-inclined and interested in metaphysical stones, meditation rocks, and spiritual gifts. It's an ideal agate gift, geology gift or rock hound gift.
Width of each half: About 2.95" (7.5 cm)
Height of each half: About 2.55" (6.5 cm)
Total weight: 15.27 oz (433 oz)
You will get this exact sliced agate specimen when you buy.